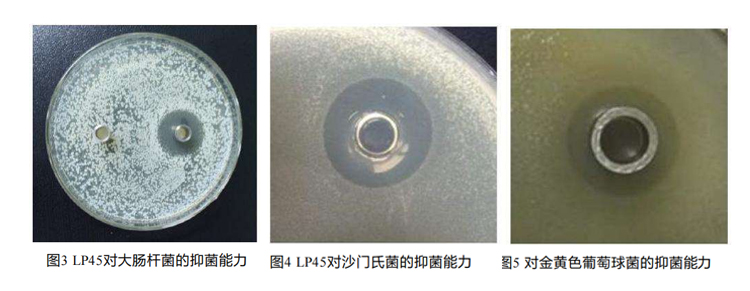
05.jpg

电话:15618263001
地址:上海市普陀区礼尚路222弄高尚领域T3座
科研支撑


针对幽门螺杆菌—江南大学专利菌株功效验证

菌株功效验证—人群试服1
试验目的: 考察益生菌组方对幽门螺杆菌检测呈阳性人群的胃部Hp的抑制作用
受试者:35名成人(经C13检测Hp呈阳性)
产品服用量:每天早、晚各服用2条
服用周期:30天
Hp检测方法:C13检测
结果:66.7%的降低率 ,23%的阳转阴率
植物乳植杆菌LP45功能特点
耐受性好,存活率高
植物乳植杆菌LP45(YMC1005)具有非常高的抵抗人工胃液和人工肠液的特性,经过胃肠液的消化,仍能有足量的活菌数到达肠道定植,发挥益生作用。

抑制致病菌
大肠杆菌和金黄色葡萄球菌是引起食物中毒的主要菌株,分泌的肠毒素会引起分泌性腹泻、电解质紊乱和酸中毒;侵入上皮细胞时,会破坏肠粘膜,形成损伤或溃疡。植物乳植杆菌LP45分泌的抗菌素等代谢产物能有效抑制或杀灭大肠杆菌、沙门氏菌和金黄色葡萄球菌。
植物乳植杆菌LP45(动物实验)

由图4、图5可以看出,实施例5的IgG、IL-10、肠粘膜中SIgA的含量明显高于实施例6,IL-6的含量明显低于实施例6,这说明,10-羟基-2-癸烯酸与甘油质量比为1:15-20时,能够使得植物乳杆菌更加快速和高效地在肠道中定植,进而提高机体的体液免疫能力,刺激上调抗炎因子的表达,抑制促炎因子的分泌,发挥特异性免疫功能,活化肠粘膜的淋巴细胞,刺激SIgA的分泌,提高肠道粘膜免疫功能。
人体肠道实验报告


实验结论
(1)LP45+La28能促进产短链脂肪酸(SCFAs)菌属的增殖,增加肠道SCFAs含量
与服用前的菌群相比,服用LP45后,肠道中与产短链脂肪酸(SCFAs)相关的菌属都有明显的增长,如
Lachnospiraceae(毛螺菌科)中的Lachnospira(毛螺菌属)、Blautia(布劳特氏菌属)以及 Ruminococcaceae(瘤胃 菌科)中
的Faecalibacterium、Oscilospir(颤螺菌属)等,使肠道中短链脂肪酸的含量显著增加。
(2)LP45+La28能促进双歧杆菌、乳杆菌等常见有益菌的增殖
服用LP45后,Bifidobacterium(双歧杆菌属)、Lactobacilus(乳杆菌属)、Butyricimonas(丁酸弧菌 )、
Parabacteroides这些常见的益生菌都在受试者肠道菌群有明显的增长。
(3)LP45 +La28能抑制肠道条件致病菌
同时,肠道粪便菌群中条件致病菌的相对丰度降低了,说明LP45能抑制致病菌的增殖。
LP45+La28能促进有益菌的增长,同时抑制有害菌;增加肠道短链脂肪酸(SCFAs)的含量!
嗜酸乳杆菌La28—抗流感病毒;吸附有害物质
科学验证


服用La28和LP45菌株后病理损伤程度较模型组明显减轻,肺组织及周围的炎症细胞浸润明显减少、黏膜上皮轻度增生、 气道上皮损伤减轻及肺泡间隔增厚程度减轻; 并阻止病毒的释放, 减轻了流感呼吸道炎症。
每一株菌株的功效,都不是凭空而来的承诺;每一份安心的背后,都是皓畅对科研严谨性的坚守。我们始终相信,真正有价值的产品,需要扎实的试验数据作为支撑,需要科学的验证来保驾护航。
如果你对我们的菌株功效还有任何疑问,或者想了解更多科研细节,欢迎在评论区留言,我们会一一为你解答。关注皓畅,让科学健康与你同行~